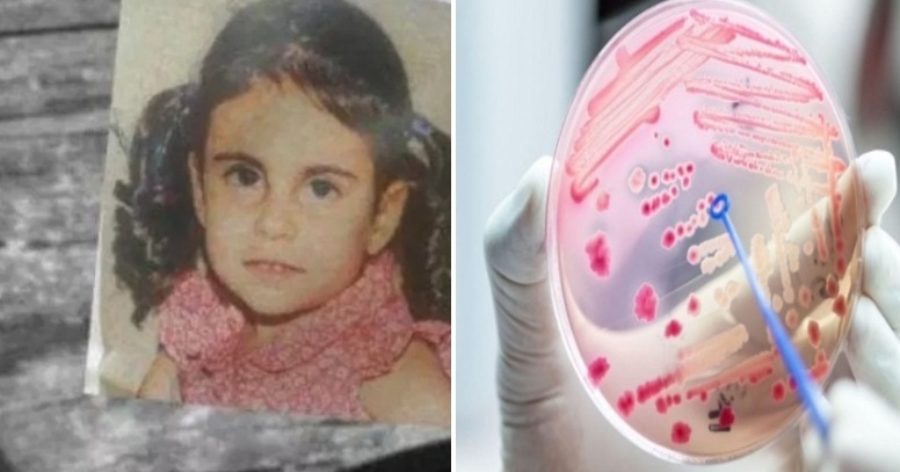

Η 5χρονη Εύχαρις, είναι το πρώτο παιδί θύμα της γρίπης Η1Ν1 για τη φετινή χρονιά. Σύμφωνα και με τα χθεσινά εργαστηριακά αποτελέσματα η 5χρονη δεν είχε προσβληθεί από μηνιγγίτιδα όπως υπήρξαν φόβοι αλλά ανιχνεύθηκε σταφυλόκοκκος στον πνεύμονα, με αποτέλεσμα να προκληθεί στον οργανισμό της «κεραυνοβόλο» σηπτικό σοκ και το παιδάκι – σε συνδυασμό με τον Η1Ν1 από τον οποίο είχε νοσήσει – να «σβήσει» μέσα σε λίγες μόνο ώρες.
Ο πατέρας της μικρής σε μια εκ βαθέων εξομολόγησή τους στο protothema.gr συγκινεί λέγοντας ότι «Την ώρα που οι γιατροί την είχαν στην αγκαλιά τους και έδιναν μάχη να την κρατήσουν στη ζωή, δεν θα ξεχάσω ότι η Εύχαρις προσπάθησε να αγκαλιάσει τη μαμά της για τελευταία φορά αλλά δεν πρόλαβε. Ήταν ένα χαρούμενο, ζωηρό κοριτσάκι που μας έδινε ζωή και τώρα προσπαθούμε να συνέλθουμε από τον ξαφνικό θάνατό της».
Τι δήλωσε ο γιατρός της 5χρονης για τον αιφνίδιο θάνατό της
Στο πλαίσιο έκτακτης συνέντευξης τύπου που παραχώρησαν σήμερα τα στελέχη της 7ης ΥΠΕ Κρήτης, μίλησε και ο Μανώλης Γαλανάκης, Καθηγητής παιδιατρικής, θεράπων ιατρός της 5χρονης ανέφεροντας εξής: “Έχουμε απομονώσει τον ιό. Η μέθοδος που απομονώθηκε είναι ασφαλής. Η γρίπη έχει κακούς τύπους, κι ένας από αυτούς ήταν κι αυτός. Ο συνδυασμός σταφυλόκοκκου και γρίπης αρκούν για να καταλήξει ένας άνθρωπος. Είναι λοιμογονος συνδυασμός. Δεν έχουμε βρει καμία ένδειξη για μηνιγγίτιδα μέχρι τώρα. Μίλησαμε με το σχολείο και πήραν τα απαραίτητα μέτρα, υπό τον φόβο μηνιγγιτιδοκοκκου. Να εμβολιάζονται μόνο τα πολύ ευπαθή παιδιά (όπως αυτά με άσθμα)”
Από την πλευρά του ο καθηγητής Παθολογίας και ειδικός στις λοιμώξεις στο ΠΑΓΝΗ Αχιλλέας Γκίκας σημείωσε: Κάθε χρόνο η εξέλιξη της επιδημίας έχει διαφορετική καμπύλη. Η φετινή είναι όπως η περυσινή και η προπερσινη. Μιλάμε για ένα συνηθισμένο αριθμό γρίπης και δυστυχώς έναν συνηθισμένο αριθμό θανάτων. Η εξέλιξη της επιδημίας είναι στο προβλεπόμενο πλαίσιο. Το 80% ήταν ανέμβολιαστοι. Οι ευπαθείς ομάδες επιβάλλεται να εμβολιαστούν. Επιτέλους, ας εμβολιαστούμε όταν έχουμε παράγοντες κινδύνου. Για τους υπόλοιπους δεν επιβάλλεται, απλά προσφέρεται. Η Κρήτη διαχρονικά έχει τον μικρότερο αριθμό θανάτων. Δεν είχαμε ξανά θάνατο μικρού παιδιού. Δυστυχώς είχαμε φέτος. Μακάρι να μην ξαναεχουμε. ”
O γιατρός Μανώλης Λουμπουνης τόνισε “Έγινε μια προσπάθεια χθες για να καθησυχάσουμε τους γονείς, να τους πείσουμε ότι δεν υπάρχει μολυσμένο σχολείο και περιβάλλον. Δεν υπάρχει λόγος να μην πηγαίνουν τα παιδιά στο σχολείο. Το εντυπωσιακό ήταν ότι ήρθαν οι γονείς της 6χρονης και ζήτησαν να μην αναβληθεί καμία προγραμματισμένη εκδήλωση. Πραγματικά θαυμάζω τη γενναιότητα και το θάρρος αυτών των ανθρώπων.